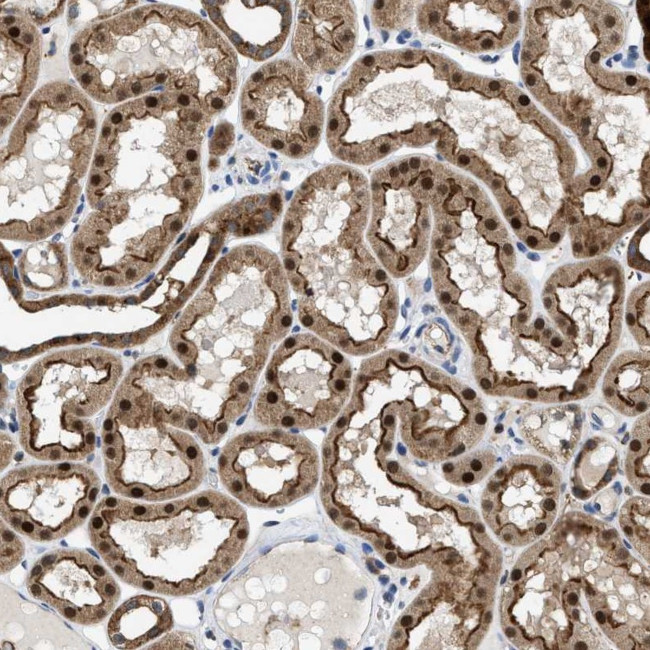
ENPP4 Antibody in Immunohistochemistry (Paraffin) (IHC (P))

Search
Invitrogen
ENPP4 Polyclonal Antibody
{{$productOrderCtrl.translations['antibody.pdp.commerceCard.promotion.promotions']}}
{{$productOrderCtrl.translations['antibody.pdp.commerceCard.promotion.viewpromo']}}
{{$productOrderCtrl.translations['antibody.pdp.commerceCard.promotion.promocode']}}: {{promo.promoCode}} {{promo.promoTitle}} {{promo.promoDescription}}. {{$productOrderCtrl.translations['antibody.pdp.commerceCard.promotion.learnmore']}}

Please note: We are reviewing Western blot images included in the antibody testing data in our catalog, including those provided by third parties. Unless expressly labeled or annotated as “raw-unedited”, Western blot images included in the antibody testing data in our catalog may have been edited, optimized or otherwise adjusted for presentation.
产品信息
PA5-53454
种属反应
宿主/亚型
分类
类型
抗原
偶联物
形式
浓度
规格
纯化类型
保存液
内含物
保存条件
运输条件
RRID
产品详细信息
Immunogen sequence: DEGWTIVLNE SSQKLGDHGY DNSLPSMHPF LAAHGPAFHK GYKHSTINIV DIYPMMCHIL GLKPHPNNGT FGHTKCLLVD QW
Highest antigen sequence identity to the following orthologs: Mouse - 88%, Rat - 88%.
靶标信息
NPP4, also known as ENPP4 (ectonucleotide pyrophosphatase/phosphodiesterase family member 4), is a 453 amino acid single-pass type I membrane protein that belongs to the nucleotide pyrophosphatase/phosphodiesterase family. The gene that encodes NPP4 consists of approximately 16, 736 bases and maps to human chromosome 6p21.1. Making up nearly 6% of the human genome, chromosome 6 contains around 1, 200 genes within 170 million base pairs of sequence. Deletion of a portion of the q arm of chromosome 6 is associated with early onset intestinal cancer suggesting the presence of a cancer susceptibility locus. Porphyria cutanea tarda is associated with chromosome 6 through the HFE gene, and Stickler syndrome, 21-hydroxylase deficiency and maple syrup urine disease are also associated with genes on chromosome 6. Notably, the PARK2 gene, which is associated with Parkinson's disease, and the genes encoding the major histocompatibility complex proteins are also located on chromosome 6. A bipolar disorder susceptibility locus has been identified on the q arm of chromosome 6.
仅用于科研。不用于诊断过程。未经明确授权不得转售。
篇参考文献 (0)
生物信息学
蛋白别名: AP3A hydrolase; AP3Aase; Bis(5'-adenosyl)-triphosphatase ENPP4; E-NPP 4; Ectonucleotide pyrophosphatase/phosphodiesterase family member 4
基因别名: ENPP4; KIAA0879; NPP4
Entrez Gene ID: (Human) 22875